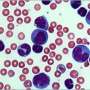

Dear Reader ,
Here is your customized Science X Newsletter for June 24, 2016:
Spotlight Stories Headlines
Astronomy & Space news
![]() | Image: Hubble sees new dark spot on NeptuneNew images obtained on May 16, 2016, by NASA's Hubble Space Telescope confirm the presence of a dark vortex in the atmosphere of Neptune. This full visible-light image shows that the dark feature resides near and below a patch of bright clouds in the planet's southern hemisphere. Though similar features were seen during the Voyager 2 flyby of Neptune in 1989 and by the Hubble Space Telescope in 1994, this vortex is the first one observed on Neptune in the 21st century. |
![]() | Measuring the shape of the Milky Way's black holeAt the heart of our galaxy's center is SagA*, a supermassive black hole containing about four million solar-masses of material. SgrA* is relatively faint, unlike the supermassive black holes in some other galaxies. This is probably because, unlike its active cousins, it is not aggressively accreting material and so is neither heating up its environment nor ejecting particularly intense jets of fast-moving charged particles. Of course, it is also faint because it is located about twenty-five thousand light years from Earth and because it is shrouded in absorbing, intervening dust. Nevertheless, radiation at radio, submillimeter, infrared and X-rays can penetrate the veiling material. As the closest super massive black hole to Earth, SgA* is a template for astronomers actively studying black holes, offering the best views of the physical properties and environments. The radio emission in particular is thought to come from material falling onto a disk around the black hole and heating up electrons, and from ejected material both within the jet itself and its nozzle. |
NASA extends Hubble Space Telescope science operations contractNASA is contractually extending science operations for its Hubble Space Telescope an additional five years. The agency awarded a sole source contract extension Thursday to the Association of Universities for Research in Astronomy for continued Hubble science operations support at the Space Telescope Science Institute in Baltimore. | |
![]() | Underground astronauts preparing for spaceWe usually send them 400 km up, but next week ESA will be sending six astronauts 800 m underground into the rocky caves of Sardinia, Italy. The caving course recreates aspects of a space expedition with an international crew and has become an essential part of ESA's astronaut training. |
![]() | Can Boeing launch a crewed starliner by February 2018?Boeing thinks it can have its Starliner spacecraft ready to fly crewed missions by February, 2018. This is 4 months later than the previous date of October 2017. It isn't yet clear what this will mean in Boeing's race against SpaceX to relieve NASA's dependence on Russian transportation to the ISS. |
![]() | Time for NASA to double down on journey to MarsSince the Authorization Act of 2010, NASA has been pushing ahead with the goal of sending astronauts to Mars by the 2030s. The latter part of this goal has been the subject of much attention in recent years, and for good reason. Sending crewed missions to the Red Planet would be the single-greatest initiative undertaken since the Apollo era, and the rewards equally great. |
![]() | Image: Hubble gazes at stars of the Large Magellanic CloudThis colorful and star-studded view of the Milky Way galaxy was captured when the NASA/ESA Hubble Space Telescope pointed its cameras towards the constellation of Sagittarius (The Archer). Blue stars can be seen scattered across the frame, set against a distant backdrop of red-hued cosmic companions. This blue litter most likely formed at the same time from the same collapsing molecular cloud. |
![]() | Research signals start-up boost for laptop usersA British tech start-up has invented a world-first multi-function antenna for laptops that fits into the extremely limited space of the hinge cavity. |
![]() | Atlas rocket launches for 1st time since March groundingAmerica's Atlas rockets are flying again, successfully launching a communications satellite for the Navy. |
NASA launches suborbital rocket carrying student experimentsNASA says it has successfully launched a suborbital rocket carrying student experiments from its Wallops Flight Facility on Virginia's Eastern Shore. | |
Technology news
![]() | Passenger may be protected less than driver, says studyFront-seat passengers should know they may be getting less protection than the driver. A new study has taken a close look at what happens in certain types of crashes. |
![]() | How well do facial recognition algorithms cope with a million strangers?In the last few years, several groups have announced that their facial recognition systems have achieved near-perfect accuracy rates, performing better than humans at picking the same face out of the crowd. |
![]() | Borophene could be an extraordinary sodium anode material for sodium-based batteriesSodium-based batteries are a prospective alternative to lithium-based batteries due to the abundance and low price of sodium. However, finding a suitable anode material has been a longstanding hurdle to the commercialization of sodium-based batteries. As the size of the sodium atom is much larger than lithium, many anode materials widely used in lithium-based batteries show poor performance in sodium-based batteries, most of which suffer from low intercalation utility, slow kinetics and sever volume expansion. |
![]() | New device could unlock information potential of sunlightPeople rely on sunlight for heat, light, and energy every day, but three Penn State researchers believe we're missing a valuable piece of information that sunlight itself could provide—the dynamic directions of incoming light. |
![]() | Flower power—photovoltaic cells replicate rose petalsWith a surface resembling that of plants, solar cells improve light-harvesting and thus generate more power. Scientists of KIT (Karlsruhe Institute of Technology) reproduced the epidermal cells of rose petals that have particularly good antireflection properties and integrated the transparent replicas into an organic solar cell. This resulted in a relative efficiency gain of twelve percent. An article on this subject has been published recently in the Advanced Optical Materials journal. |
![]() | Computer sketches set to make online shopping much easierA computer program that recognises sketches pioneered by scientists from Queen Mary University of London (QMUL) could help consumers shop more efficiently. |
Tech company Twilio nearly doubles in stock market debutTwilio shares nearly doubled in their first day of trading Thursday, after the technology company raised $150 million in its initial public offering. | |
![]() | VW to pay near $10.2B to settle emissions claimsVolkswagen will spend about $10.2 billion to settle an emissions cheating scandal in the U.S. that has turned into one of the largest cases of corporate deception in the nation's history. |
Use of drones for disaster missions put to the testHow to distribute lifesaving supplies quickly and safely after a natural disaster has long been a puzzle for responders. Now, drones might be the lifesaver. | |
S. Korea mulls law to keep office out of the homeHyper-wired South Korea is considering legislation that would ban bosses from bothering their staff at home, after growing complaints about the country's already onerous work-life imbalance. | |
![]() | Software engineers create new defense to protect Tor usersResearchers from TU Darmstadt developed successfully in collaboration with the University of California Irvine a new protection for Tor users. "Selfrando" strengthens the Tor Browser against attempts to hack and de-anonymize Tor users. |
![]() | Would you live in a city made of synthetic bone?The cities of today are built with concrete and steel – but some Cambridge researchers think that the cities of the future need to go back to nature if they are to support an ever-expanding population, while keeping carbon emissions under control. |
![]() | Mapping online hate speechYou might think from anecdotal evidence that hate speech on social media by individuals and groups appears quite a lot, but one of first academic studies to examine the empirical data concludes that these extreme forms of speech on Facebook are marginal as compared with total content. |
Researchers study nuances of social media 'likes'The simple act of pressing a "like" button on a social media site can speak volumes about a user's preferences, relationships and behavioral patterns, according to Penn State researchers, and such findings about a user could help improve and personalize services. The ultimate goal of their multi-year project, LIKEs-R-Us, is to leverage the data they have collected into developing enhanced technologies that assist users in their social networking and online activities. | |
![]() | NASA launches 5-year tech demo to improve air traffic flow at airportsNASA is working toward a greener future in aviation, where airplanes push back from the gate, taxi to the runway and take off much quicker. A more efficient, precise trip by an airplane from the gate to takeoff reduces the amount of time its jet engines spend running on the ground, reduces noise and emissions levels at the airport, and reduces the time you spend sitting and waiting to take off. |
![]() | Pinpointing vehicles with high precision under adverse weather conditionsDuring a mid-March snowstorm, researchers from MIT Lincoln Laboratory achieved real-time, nighttime, centimeter-level vehicle localization while driving a test vehicle at highway speeds over roads whose lane markings were hidden by the snow. The sport utility vehicle used in the demonstration was equipped with a system that employs a novel ground-penetrating radar technique to localize the vehicle to within centimeters of the boundaries of its lane. The technique could solve one of the problems limiting the development and adoption of self-driving vehicles: How can a vehicle navigate to stay within its lane when bad weather obscures road markings? |
![]() | What's wrong with the web and do we need to fix it?More than 20 years after the first web server started bringing the internet into our lives, a recent conference in San Francisco brought together some of its creators to discuss its future. |
Augmented reality can increase slaughterhouse production yieldNew research explores the potential impact augmented reality has on systems in slaughterhouses. Augmented Reality has provided lucrative new solutions in industrial quality assurance systems. Now, new research published in Cogent Food & Agriculture explores the potential impact of this new technology on systems in slaughterhouses. | |
![]() | Researchers discover the key to optimizing information transferEPFL researchers have come up with a way to optimize information transfer, solving a problem that has confounded researchers for 60 years. Their breakthrough could enhance the quality of our communications, from smartphones to satellite transmissions and data storage. |
![]() | Low queer-factor in computer games reportedSome computer games provide players with gay characters. At the same time, however, the gay characters can always be deselected. Where is the diversity in the gaming world? asks Norwegian game researcher. |
![]() | Plasmapour technology set to revolutionise the metal industryThe "just in time" principle applied to temperature control promises gains in energy efficiency and product quality. |
![]() | Coal to solar: Retraining the energy workforceAs more coal-fired power plants are retired, industry workers are left without many options. There is a light at the end of the tunnel, though. |
Lottery firm says its 'most-prized' secrets have been takenA key executive of a company that works with more than 40 state lotteries in the U.S. orchestrated a "massive theft" of its most-prized secrets before he resigned to accept a position with a rival company, his former employer said in a federal lawsuit. | |
![]() | Algorithmic solutions to manufacturing freeform shapesA toolbox of algorithms that can be consulted and applied in order to cost-effectively manufacture freeform shapes has been developed by EU researchers. |
Russia adopts controversial counter-terrorism amendmentsThe Russian parliament on Friday adopted a set of controversial counter-terrorism amendments which have sparked alarm among rights activists. | |
Medicine & Health news
![]() | Researchers discover how faulty genetic instructions drive a deadly blood cancer in adultsScientists have previously identified a series of genetic errors that commonly occur inside cancerous blood cells, but it hasn't been clear exactly how those genetic malfunctions create immature blood cells that overpopulate, crowd out healthy cells and spread in patients with acute myeloid leukemia or AML. Now, researchers at the University of North Carolina Lineberger Comprehensive Cancer Center have discovered how a set of faulty genetic instructions keep blood stem cells from maturing, a finding that further explains the development of AML. |
![]() | Male mitochondrial DNA found to self-destruct after arrival in embryoA team of researchers with members from Taiwan, the U.S., China and Japan has found that mitochondrial DNA from sperm that makes its way into an embryo begins to self-destruct before autophagosomes in the cytoplasm can reach it. In their paper published in the journal Science, the researchers describe their study involving the close monitoring of male mitochondrial DNA activity immediately after an embryo has been fertilized and as it is subsequently destroyed—they also offer some theories regarding why this occurs. |
![]() | Real life brain studies: 3D brain-on-a-chipTo study brain cell's operation and test the effect of medication on individual cells, the conventional Petri dish with flat electrodes is not sufficient. For truly realistic studies, cells have to flourish within three-dimensional surroundings. Bart Schurink, researcher at University of Twente's MESA+ Institute for Nanotechnology, has developed a sieve with 900 openings, each of which has the shape of an inverted pyramid. On top of this array of pyramids, a micro-reactor takes care of cell growth. Schurink defends his PhD thesis June 23. |
![]() | New cancer immunotherapy drugs linked to arthritis in some patientsCase reports on 13 cancer patients suggest that a small number of cancer patients taking the immunotherapy drugs ipilimumab and nivolumab may be at some higher-than-normal risk of developing autoimmune joint and tissue diseases, including inflammatory arthritis, according to a preliminary study by Johns Hopkins Medicine researchers. |
![]() | Senators reach deal on GMO labelingSenators have a bipartisan deal to require labeling of genetically modified ingredients nationally, a week before a labeling law in Vermont goes into effect. |
Longevity and human health may be linked to a muscle cell enzymeExercise and fasting do not change the location of a key enzyme involved in energy production, a study in Experimental Physiology found. | |
![]() | Depression decreases adherence to COPD maintenance medicationsA recent study in the Annals of the American Thoracic Society found that in a nationally representative sample of Medicare beneficiaries who were newly diagnosed with COPD, adherence to maintenance medications decreased with new episodes of depression. |
Guided procedures ensure accuracy of therapeutic injectionsWhen it comes to pain in the hip, knee or shoulder that requires therapeutic injections, be sure to seek a physician who is trained in image-guided procedures to deliver the medication accurately, says a physical medicine and rehabilitation expert at Baylor College of Medicine. | |
![]() | Sports engineers aim to give Tour cyclists the edgeUniversity of Adelaide sports engineers have teamed up with Swiss company Scott Sports to help develop what is believed to be the world's fastest road cycling helmet – and it will be put to the ultimate test by an Australian cycling team in competition at next month's Tour de France. |
New doubts on Zika as cause of microcephalyBrazil's microcephaly epidemic continues to pose a mystery—if Zika is the culprit, why are there no similar epidemics in other countries also hit hard by the virus? In Brazil, the microcephaly rate soared with more than 1,500 confirmed cases. But in Colombia, a recent study of nearly 12,000 pregnant women infected with Zika found zero microcephaly cases. If Zika is to blame for microcephaly, where are the missing cases? Perhaps there is another reason for the epidemic in Brazil. According to a new report by the New England Complex Systems Institute (NECSI), the number of missing cases in Colombia and elsewhere raises serious questions about the assumed connection between Zika and microcephaly. | |
A-grade report card on superbugs in Australian animalsThe first nationwide survey of antibiotic resistance in disease-causing bacteria in Australian pets and livestock has found low rates of resistance to critically important drugs–comparing very favourably with other countries around the world. | |
![]() | Upper limb amputees have better outcomes with prosthetics when trained by fellow amputeesNew research suggests that upper limb amputees, who typically struggle to learn how to use a new prosthesis, would be more successful if fellow amputees taught them. Most usually learn by watching a non-amputee demonstrate the device during physical therapy and rehabilitation sessions. A Georgia Institute of Technology study that measured arm movements and analyzed brain patterns found that people do better when they learn from someone who looks like them. The paper is published in the journal Neurorehabilitation and Neural Repair. |
Detecting brain tumors' warped metabolismWhen a brain tumor is suspected because of symptoms such as headaches or other problems, its presence is usually confirmed by anatomical imaging such as CT or MRI. But through imaging, doctors often can't say much about the tumor – molecularly – besides "something's in there." Surgery and a biopsy are necessary to get a glimpse of the cancer cells themselves. | |
![]() | Factors affecting HPV vaccination ratesVirtually all cases of cervical cancer are caused by human papillomavirus (HPV), the most common sexually transmitted infection in the U.S., but fewer than 40 percent of adolescent girls have received the three-dose vaccine developed a decade ago. |
![]() | GPs given tools to combat antibiotic overuseA pilot program aimed at stemming antibiotic resistance has successfully reduced prescribing rates among participating doctors. |
![]() | Aggressiveness of acute myeloid leukemia elucidatedAntoine Peters and colleagues at the Basel University Children's Hospital (UKBB) have discovered why acute leukemias with the same genetic abnormality vary in their aggressiveness based on their cellular origin. They found that the cancer inducing alteration is particularly devastating if it occurs in early hematopoietic stem cells expressing certain genes involved in cell migration and tissue invasion. These findings should now make it possible to classify patients into more clearly defined groups, to adapt treatment, and hopefully also to develop personalized therapeutic strategies for the future. |
![]() | Men likely to gain weight after losing jobs prior to retirementPeople who lose their jobs late in their careers are at risk of gaining weight—especially men, according to a new University of Michigan study. |
![]() | Scientists discover unsuspected bacterial link to bile duct cancerAn international research collaboration has identified bacteria in the bile duct as a potential risk factor in the development of bile duct cancer, or Cholangiocarcinoma (CCA), a rare but aggressive form of cancer with symptoms that do not present themselves at the early stages. |
![]() | Common chemical highly toxic to blood cell precursorsMalaysian scientists have provided evidence that a widely used chemical is more toxic to certain blood cell precursors in the bone marrow than to others. |
![]() | Premature girl and boy babies may need different food to thrive – and breastmilk may differ for each sexA major new Auckland study will investigate whether giving specially boosted nutrition to preterm babies in the first crucial days of life could prevent diseases later in life and help intellectual development. It will also look at whether this optimal nutrition may differ for boys and girls. |
![]() | Legislators who prioritize fighting cancer more likely to base decisions on researchState legislators who prioritize cancer control may be more receptive to basing their decisions on research evidence than policy makers interested in other issues, finds a new study from Washington University in St. Louis. |
![]() | Beyond the sweetness of sugarWe all know the nutritional "evils" of sugar as a potential cause of obesity, chronic disease and death, through to being a potentially brain damaging substance. |
![]() | Analysis of genetic repeats suggests role for DNA instability in schizophreniaInternational researchers centered at Nagoya University use a highly sensitive technique to identify significantly more DNA sequence repeats in patients with schizophrenia than in control individuals, and outline a possible link between genome instability and disease. |
![]() | Faster detection of pathogens in the lungsWhat used to take several weeks is now possible in two days: Thanks to new molecular-based methods, mycobacterial pathogens that cause pulmonary infections or tuberculosis can now be detected much more quickly. Time-consuming bacteria cultures no longer need to be taken from the patient samples, meaning that a suitable therapy can be started quickly. |
![]() | X-ray study reveals distribution of the toxic metalloid in leavesToxic arsenic initially accumulates in the nuclei of plants' cells. This has been revealed by an X-ray examination of the aquatic plant rigid hornwort (Ceratophyllum demersum) using DESY's X-ray source PETRA III. Even at comparatively low concentrations, the arsenic also floods the vacuole, a liquid-filled cavity which takes up most of the cell. Researchers surrounding Hendrik Küpper of the Czech Academy of Sciences, who is a professor at the University of South Bohemia in Ceské Budejovice (Czech Republic), have made this discovery in the course of a project that was set up in Küpper's group by Seema Mishra (now at the National Botanical Research Institute in Lucknow, India). The scientists report their findings in the Journal of Experimental Botany. |
Eyewitnesses who collaborate make fewer mistakes in police interviewWitnesses correct each other's errors. Two recently published research studies by legal psychologists Annelies Vredeveldt and Peter van Koppen at Vrije Universiteit Amsterdam show that witnesses make fewer errors when they are interviewed together than when they are interviewed separately. This stands in sharp contrast with current police guidelines to always interview witnesses separately. | |
The use of non-fit messaging may improve patient choicesWhen it comes to helping patients make the best choices for themselves, sometimes you have to challenge their usual way of dealing with the world, according to new research published by the Society for Personality and Social Psychology. | |
In mice, daughters of overweight dads have altered breast tissue, higher cancer riskObese male mice and normal weight female mice produce female pups that are overweight at birth through childhood, and have delayed development of their breast tissue as well as increased rates of breast cancer. | |
![]() | How does climate affect violence? Researchers offer new theoryResearchers have long struggled to explain why some violent crime rates are higher near the equator than other parts of the world. Now, a team of researchers have developed a model that could help explain why. This new model goes beyond the simple fact that hotter temperatures seem to be linked to more aggressive behavior. Paul van Lange, a professor of psychology at Vrije Universiteit Amsterdam along with Maria I. Rinderu (VU Amsterdam) and Brad Bushman, a professor of psychology at The Ohio State University and VU Amsterdam developed a new model - called CLASH (CLimate Aggression, and Self-control in Humans). They describe the CLASH model in an online article in the journal Behavioral and Brain Sciences. |
![]() | 3D-printed kidney helps doctors save woman's organ during complicated tumor removalDoctors and scientists at Intermountain Medical Center in Salt Lake City printed and used a 3D kidney to help save a patient's organ during a complicated tumor-removal procedural. |
Making a life plan based on your DNALee and his wife are the first patients of Dan Carlin to have their entire genome mapped. | |
![]() | Drug abuse program explores problems such as racism, incarcerationThe creators of a novel substance abuse treatment program have received an infusion of funding from a federal agency for an expanded study of their intervention, which targets marginalized populations who struggle with problems such as racism, sexism, poverty and histories of incarceration. |
![]() | Regenerative medicine offering new treatment for bronchopleural fistulasFor the first time in human application, Mayo Clinic researchers successfully closed an open wound on the upper chest caused by postoperative complications of lung removal. |
Cross talk between hormone receptors has unexpected effectsOne of the first clues pathologists look for in tissue from a newly diagnosed breast cancer patient is the estrogen receptor, a nuclear protein that converts hormonal messages in the bloodstream into instructions for the cell about how to behave. They also look for the presence of progesterone receptors, primarily to confirm that the estrogen receptor is active. | |
![]() | Beneficial bacteria may protect breasts from cancerBacteria that have the potential to abet breast cancer are present in the breasts of cancer patients, while beneficial bacteria are more abundant in healthy breasts, where they may actually be protecting women from cancer, according to Gregor Reid, PhD, and his collaborators. These findings may lead ultimately to the use of probiotics to protect women against breast cancer. The research is published in the ahead of print June 24 in Applied and Environmental Microbiology, a journal of the American Society for Microbiology. |
![]() | Primary care visits result in more colon cancer screening, better followupsPeople who visit their primary care physicians are more likely to get potentially life-saving colon cancer screenings and follow up on abnormal stool blood test results - even in health systems that heavily promote mail-in home stool blood tests that don't require a doctor visit, a study involving UT Southwestern population health researchers shows. |
![]() | Combination therapy may hold the key to slowing down Alzheimer's diseaseResveratrol is a naturally occurring polyphenolic phytochemical produced in several plants, especially grapes skin and seeds. One epidemiological study reported a positive association between moderate red wine consumption and a low incidence of cardiovascular disease, known as the "French Paradox." T |
New devices causing 'paradigm shift' in stroke careNew devices called stent retrievers, which effectively reverse strokes, have revolutionized the treatment of certain stroke patients, according to an article in the journal Expert Review of Neurotherapeutics. | |
Researchers investigate prevalence of gingivitis during first / second trimesters of pregnancyToday at the 94th General Session & Exhibition of the International Association for Dental Research, researcher Michael Reddy, University of Alabama at Birmingham, USA, will present a study titled "Gingivitis During the First/Second Trimesters of Pregnancy." The IADR General Session is being held in conjunction with the 3rd Meeting of the IADR Asia Pacific Region and the 35th Annual Meeting of the IADR Korean Division. | |
Further characteristics of jaw injury and TMD: The OPPERA studyToday at the 94th General Session & Exhibition of the International Association for Dental Research, researcher Sonia Sharma, University at Buffalo, N.Y., USA, will present a study titled "Further Characteristics of Jaw Injury and TMD: The OPPERA Study." The IADR General Session is being held in conjunction with the 3rd Meeting of the IADR Asia Pacific Region and the 35th Annual Meeting of the IADR Korean Division. | |
Effectiveness of SDF in arresting root caries in different fluoridated areasOn June 24, 2016, at the 94th General Session & Exhibition of the International Association for Dental Research, researcher Edward Lo, University of Hong Kong, SAR, China, will present a study titled "Effectiveness of SDF in Arresting Root Caries in Different Fluoridated Areas." The IADR General Session is being held in conjunction with the 3rd Meeting of the IADR Asia Pacific Region and the 35th Annual Meeting of the IADR Korean Division. | |
Chemical signal can make it easier to personalize medicationCommon diseases like allergy, diabetes and other immune diseases have increased dramatically in recent decades. This indicates that the environment may have a more important role than genes in explaining this increase. | |
Development of drugs for local treatment of oral conditionsOn June 24, 2016, at the 94th General Session & Exhibition of the International Association for Dental Research, researcher W. Peter Holbrook, University of Iceland, will present a study titled "Development of Drugs for Local Treatment of Oral Conditions." The IADR General Session is being held in conjunction with the 3rd Meeting of the IADR Asia Pacific Region and the 35th Annual Meeting of the IADR Korean Division. | |
Overweight and obesity impact on periodontitis: A Brazilian birth cohortToday at the 94th General Session & Exhibition of the International Association for Dental Research, researcher Marco Peres, The University of Adelaide, South Australia, will present a study titled "Overweight and Obesity Impact on Periodontitis: A Brazilian Birth Cohort." The IADR General Session is being held in conjunction with the 3rd Meeting of the IADR Asia Pacific Region and the 35th Annual Meeting of the IADR Korean Division. | |
Illinois insurance co-op sues feds over health law paymentsA struggling Illinois health insurance co-op is suing the federal government, claiming it is being shortchanged $72.8 million in promised payments under the Affordable Care Act. | |
![]() | Solving a mitochondrial mysteryWhen it comes to mitochondrial inheritance, maternal genes rule the day at the expense of paternal ones. But why? |
![]() | New treatment approaches to improve peritoneal dialysisOne of the main functions of the kidneys is to filter metabolic products out of the blood. If the kidneys are no longer able to do this, the blood has to be artificially purified and drained of excess fluid. This is the purpose of dialysis. Around 10% of the current 5,000 or so dialysis patients in Austria use the flexible method of peritoneal dialysis, in which the peritoneal membrane is used as a filter. Peritoneal dialysis allows them to the mobile and independent. However, after a short time, the peritoneum can become "exhausted", if important endogenous protective mechanisms fail to act to protect against the dialysis fluids. To look into this and to find new therapeutic approaches, the Christian Doppler Laboratory for "Molecular stress research in peritoneal dialysis" has now been set up at MedUni Vienna. |
![]() | MicroRNAs identified as novel targets for treating asthmaA new study shows that microRNAs, which are small, noncoding RNA molecules that can silence genes, have an important role in inducing asthma. Regulating the function of specific miRNAs identified in the study could represent a new approach to asthma therapy, according to an article in Stem Cells and Development. |
![]() | Health insurer's limit on insulin pumps worries patientsStephanie Rodenberg-Lewis wasn't happy with her insulin pump and finally switched two years ago to another brand. Now her health insurer is pushing her to go back. |
![]() | Senator renews scrutiny of pharma ties on federal panelA high-ranking Senate Democrat is pushing for more answers on why doctors and patient advocates with financial ties to the pharmaceutical industry came to serve on a panel that advises the federal government on pain issues. |
Biology news
![]() | "Amazing protein diversity" is discovered in the maize plantThe genome of the corn plant – or maize, as it's called almost everywhere except the US – "is a lot more exciting" than scientists have previously believed. So says the lead scientist in a new effort to analyze and annotate the depth of the plant's genetic resources. |
![]() | Researchers discover two redox cascades that regulate chloroplast function and contribute to plant survivalA fundamental challenge of the plant life cycle is how to manage fluctuating environmental conditions. To preserve the integrity and efficiency of photosynthesis, chloroplasts have evolved multiple adaptive strategies to changes in light environments. The thiol-based redox regulation system is important for controlling chloroplast functions in response to light signal. This system has been traditionally considered to be supported only by ferredoxin-thioredoxin reductase (FTR)/thioredoxin (Trx) redox cascade. However, emerging genomics and proteomics data indicate that chloroplasts have a complex redox network, not a simple one-directional cascade. |
How elephantnose fish switch between electrical and visual senseThe elephantnose fish explores objects in its surroundings by using its eyes or its electrical sense – sometimes both together. Zoologists at the University of Bonn and a colleague from Oxford have now found out how complex the processing of these sensory impressions is. With its tiny brain, the fish achieves performance comparable to that of humans or mammals. The advance results have been published online in the Proceedings of the National Academy of Sciences of the United States of America (PNAS). The print issue will appear soon. | |
![]() | Decoding the rubber tree genomeResearchers at the RIKEN Center for Sustainable Resource Science (CSRS) in Japan along with collaborators at Universiti Sains Malaysia (USM) have succeeded in decoding the genome sequence for Hevea brasiliensis, the natural rubber tree native to Brazil. Published in Scientific Reports, the study reports a draft genome sequence that covers more than 93% of expressed genes, and pinpoints regions specific to the biosynthesis of rubber. |
![]() | Molecular scissors help evolutionary investigationScientists at KIT (Karlsruhe Institute of Technology) detected an important mechanism in the evolution of plant genomes: Using Arabidopsis thaliana as a model organism, they studied the formation of tandem repeat DNA sequences and found out that these sequences form if both DNA strands are broken at a significant distance from each other. For their experiments, the scientists used CRISPR/Cas system, working like a "pair of molecular scissors." The results are presented in the PNAS journal. (DOI: 10.1073/pnas.1603823113) |
![]() | Insects were already using camouflage 100 million years agoThose who go to a masked ball consciously slip into a different role, in order to avoid being recognized so quickly. Insects were already doing something very similar in the Cretaceous: They cloaked themselves in pieces of plants, grains of sand, or the remains of their prey, in order, for example, to be invisible to predators. An international research team, with participation from the University of Bonn, has now investigated such "invisibility cloaks" encased in amber. The custom-tailored "costumes" also permit conclusions about the habitat at the time. The results have now been published in the journal Science Advances. |
Scientists uncover route for finding out what makes individuals nice or nastyA University of Exeter scientist has helped develop an innovative mathematical model for exploring why some individuals evolve to be genetically programmed to be nice, while others stay nasty. | |
![]() | Hairs, feathers and scales have a lot in commonThe potential evolutionary link between hairs in mammals, feathers in birds and scales in reptiles has been debated for decades. Today, researchers of the University of Geneva (UNIGE) and the SIB Swiss Institute of Bioinformatics, Switzerland, demonstrate that all these skin appendages are homologous: they share a common ancestry. On the basis of new analyses of embryonic development, the Swiss biologists evidenced molecular and micro-anatomical signatures that are identical between hairs, feathers and scales at their early developmental stages. These new observations, published today in Science Advances, indicate that the three structures evolved from their common reptilian ancestor. |
New England cottontail making a comeback in the regionFrom their enclosures at zoos in New York and Rhode Island, the New England cottontail offers a cute distraction for visitors. | |
![]() | Analysis of media reporting reveals new information about snakebites and how and when they occurThe majority of snakebites are often perceived as being "illegitimate," meaning they're a result of intentional human contact such as handling a snake in captivity or attempting to kill or move a wild snake; however, little data exists regarding how snakebite victims come in contact with these venomous predators. A new study in Wilderness & Environmental Medicine analyzed media reports of snakebites in the United States. Investigators found that media coverage detailed victim circumstances better than current quantitative data, and that the majority of snakebites may actually be "legitimate," meaning they occur by surprise, without intentional contact, in a natural setting. |
![]() | A database just for bumble beesLook up the word "bumble," and the definition may read something like "To move or act in a confused, awkward or clumsy manner." But the bumble bee, a member of the genus Bombus, is anything but clumsy. In fact, the insects are expert aviators, alighting with precision inside flowers and vigorously shaking pollen loose from their stamens. |
![]() | Metabolic flexibility and immune defences may influence species spread, study suggestsWide-ranging species may have different levels of bacterial immunity than their rarer relatives, new research suggests. |
![]() | Female blue tits sing in the face of dangerBirdsong has long been associated with courtship or competitive behaviour. And males were often considered to be a more active singing partner than females. A team of researchers from the Vetmeduni Vienna now shows that female singing behaviour is in fact much more common than had been previously assumed. The researchers have for the first time demonstrated a connection between the song of female blue tits and the presence of a predator. This singing appears to be about their own defence and not that of their nest. The study was published in the Journal of Ornithology. |
![]() | Breakthrough in lupin genetics secures legume's futureBreaking the genetic bottleneck of the domesticated lupin plant could open up a world of possibilities for the legume in the global food industry. |
![]() | The Dead Sea—depletion of a shared natural resourceTravel to Jordan raised a lot of expectations, including that I would find a land somewhat familiar to my birthplace, Ashgabat, Turkmenistan—perhaps because of the Muslim majority of both places and the hot weather that shapes the climate of those countries. |
![]() | Does eating bamboo make it harder for pandas to reproduce?Most people get upset stomachs from time to time. Usually, a few trips to the bathroom or antibiotics solve the problem. For pandas, it's an entirely different story. Our research into panda digestion shows that pandas get upset stomachs so frequently it may help explain why it's so hard for them to reproduce. Our work may, as a result, highlight a new way to boost pandas' breeding success in captivity. |
![]() | New study highlights hidden values of open oceanWhat is the value of the open ocean? While commercial fisheries may be one of the most obvious sources of economic value the ocean provides, they are not the only one. |
![]() | New orchid species found in Philippine forest guerrilla zoneFive new orchid species have been discovered in remote Philippine mountains, protected from poaching because of an insurgency in the region, conservationists said Friday. |
Neonicotinoid pesticides cause harm to honeybeesOne possible cause of the alarming bee mortality we are witnessing is the use of the very active systemic insecticides called neonicotinoids. A previously unknown and harmful effect of neonicotinoids has been identified by researchers at the Mainz University Medical Center and Goethe University Frankfurt. They discovered that neonicotinoids in low and field-relevant concentrations reduce the concentration of acetylcholine in the royal jelly/larval food secreted by nurse bees. This signaling molecule is relevant for the development of the honeybee larvae. At higher doses, neonicotinoids also damage the so-called microchannels of the royal jelly gland in which acetylcholine is produced. The results of this research have been recently published in the eminent scientific journal PloS ONE. | |
![]() | New study shows not all protected areas are the same for giraffesA new study reports that giraffe survival and reproduction differed among five sites in Tanzania, and also differed among six national parks in East, South and West Africa. The study, by researchers at the Wild Nature Institute, Tanzania National Parks, Dartmouth College, and the School for Field Studies and published this week in the Journal of Mammalogy, found that even in national parks where animals are presumed to be safe and protected, vital rates of survival and reproduction vary widely. Dr. Derek Lee, principal scientist of the Wild Nature Institute and lead author of the study, said, "People often assume every national park is successfully protecting the wildlife there, but we found not all parks are the same for giraffes." |
Uncovering pathway that makes steroid hormones fast and efficientHow can the group of chemicals known as steroid hormones cause almost instantaneous changes in your body, like hydrocortisone inhalers with asthma? In an interview with UC Science Today, UC Berkeley researcher Polina Lishko mapped out the rapid route taken by progesterone, a female sex hormone, to trigger what's called the "power kick" in sperm that leads to fertilization. This pathway may explain how similar hormones act everywhere from the brain to the lungs. | |
This email is a free service of Science X Network
You received this email because you subscribed to our list.
If you no longer want to receive this email use the link below to unsubscribe.
https://sciencex.com/profile/nwletter/
You are subscribed as jmabs1@gmail.com

No comments:
Post a Comment